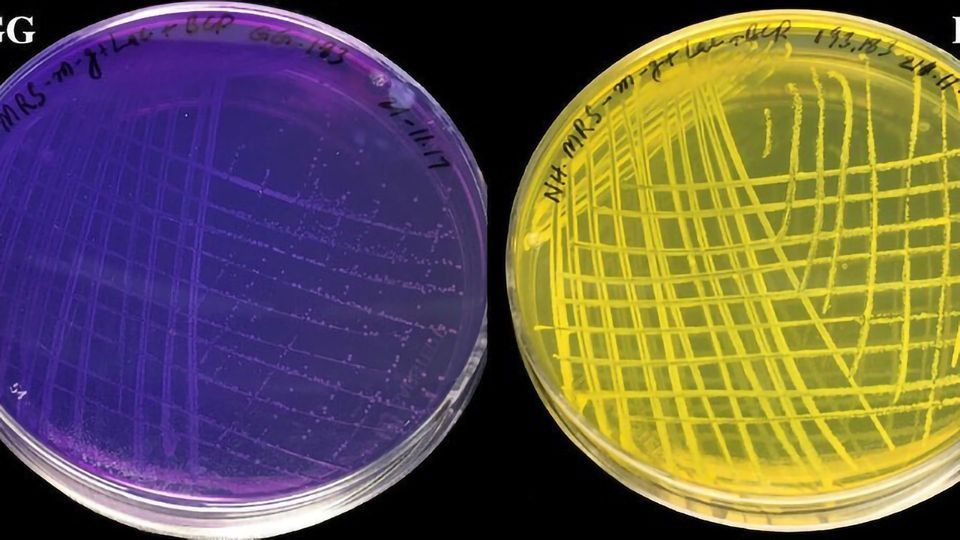
Changes to Common Probiotic Could Help Infants With Gut Issues content piece image

Changes to Common Probiotic Could Help Infants With Gut Issues
Complete the form below to unlock access to ALL audio articles.
Researchers at the University of Helsinki have created a strain of the Lacticaseibacillus rhamnosus GG probiotic that is able to utilise both lactose and casein as well as reproduce in dairy products. Consequently, the discovery can make it unnecessary to separately add the probiotic to dairy products, in addition to which it could fare better in the intestine, boosting gut health.
Lacticaseibacillus rhamnosus GG, or LGG, is the most studied probiotic bacterium in the world. However, its features are not perfect, as it is unable to utilise the milk carbohydrate lactose or break down the milk protein casein. This is why the bacterium grows poorly in milk and why it has to be separately added to probiotic dairy products.
In fact, attempts have been made to make L. rhamnosus GG better adjust to milk through genetic engineering. However, strict restrictions have prevented the use of such modified bacteria in human food.
Thanks to a recent breakthrough made at the University of Helsinki, with researchers from the National Institute for Biotechnology and Genetic Engineering, Pakistan, features have now been successfully added to the LGG probiotic without gene editing, making it thrive and grow in milk.
The method used is known as conjugation, which is a technique utilised by certain bacterial groups to transfer their traits to other bacteria. In the process, a bacterium produces a copy of its plasmid, a ring-shaped piece of DNA in the bacterium. Next, the bacterium transfers the plasmid to an adjacent bacterium. The spread of plasmids, which carry traits useful for bacteria, can be rapid among bacterial communities.
In the case of Lacticaseibacillus rhamnosus GG, the plasmid that provided the ability to make use of lactose and casein originated in a specific Lactococcus lactis bacterial strain grown in the same place.
“The new LGG strain is not genetically modified, which makes it possible to consume it and any products containing it without any permit procedures,” says the project leader, Professor of Microbiology Per Saris from the Faculty of Agriculture and Forestry, University of Helsinki.
The new strain can be used as a starting point in the development of new dairy products where the probiotic concentration increases already in the production stage. In other words, the probiotic need not be separately added to the final product.
Furthermore, the new LGG strain can potentially be better equipped to grow, for example, in the infant gut where it would be able to utilise the lactose and casein found in breastmilk, producing more lactic acid than the original strain.
“Lactic acid lowers the pH of the surface of the intestine, reducing the viability of many gram-negative pathogenic bacteria, such as E. coli, Salmonella and Shigella, which threaten the health of infants. Moreover, in larger numbers the new LGG strain can potentially be more effective at protecting infants than the old strain. After all, LGG has previously been shown to alleviate infantile atopic dermatitis and boost the recovery of the gut microbiota after antibiotic therapies.”
Reference
Hussain N et al. Generation of Lactose- and Protease-Positive Probiotic Lacticaseibacillus rhamnosus GG by Conjugation with Lactococcus lactis NCDO 712. Appl. Enviro. Micro. 87:e02957-20. DOI: 10.1128/AEM.02957-20
This article has been republished from the following materials. Note: material may have been edited for length and content. For further information, please contact the cited source.

